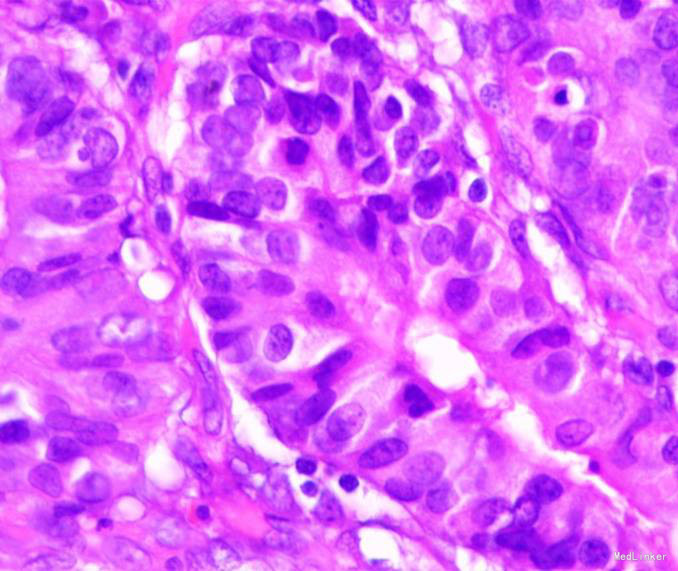

下载或打开 医联APP 查看完整评论
立即下载
打开APP
患者,男性,69岁,间歇性中上腹隐痛1月,加剧1周来我院门诊就诊,胃镜检查:见胃窦前壁处可见一1.5*2.0cm粘膜隆起,表面粗糙,见图1,胃镜诊断:胃窦粘膜隆起(性质待病理),慢性浅表性胃窦炎伴胆汁反流,10月26日门诊病理:胃窦:慢性萎缩性胃炎,急性活动,伴部分腺体中重度不典型增生,局灶重度不典型增生。于2015年10月28日入院。


查体:神志清楚,Bp:140/80mmHg,体温正常,皮肤粘膜无瘀斑瘀点,浅表淋巴结未触及,两肺呼吸音清,心率78次/分,律齐,腹软,无压痛反跳痛,移动性浊音阴性,肠鸣音正常4次/分,双下肢无浮肿。 辅助检查:血常规、血凝常规、肝肾功能、电解质均正常。 心电图:正常,胸片:无异常




诊疗经过:入院后经过术前检查,行放大内镜检查和超声内镜检查,超声内镜提示:胃窦病灶未突破粘膜下层,诊断考虑:胃早癌。于10月30日行内镜下胃ESD术,术顺,安返病房。经过过制酸、补液等对症处理,3天后患者顺利出院。

随访:出院后2周,电话随访患者,一般情况良好,无不适主诉。 讨论:该患者胃镜见一胃窦前壁粘膜隆起,表面粘膜粗糙,病理示:慢性萎缩性胃炎,伴部分腺体中重度不典型增生,局灶重度不典型增生,超声胃镜病灶未突破粘膜下层,有胃ESD手术指征,故行全麻下胃ESD术。术后病理:胃窦前壁肿瘤:腺上皮高级别上皮同瘤,部分癌变,病变大小1.5*1.1*0.3cm,基底及切缘未见癌。说明手术成功,切缘及基底均无肿瘤侵及。对于早癌患者我们完全可以通过采用ESD方法治愈患者,胃镜下切除早癌较腹腔镜创伤更小。我和患者解释时是这样说的:腹腔镜是微创,而我们内镜下ESD则是微微创。